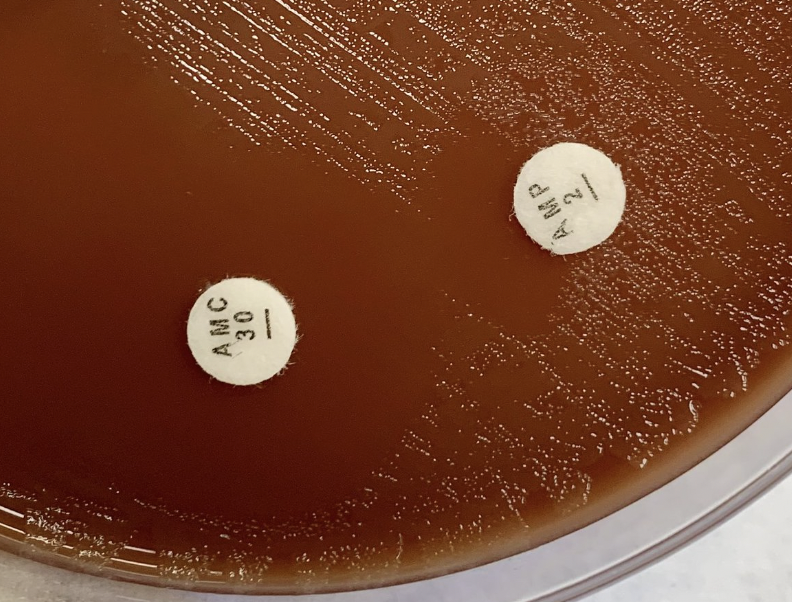
MICROBIOLOGÍA - Hospital Clínico de Valencia tweet media
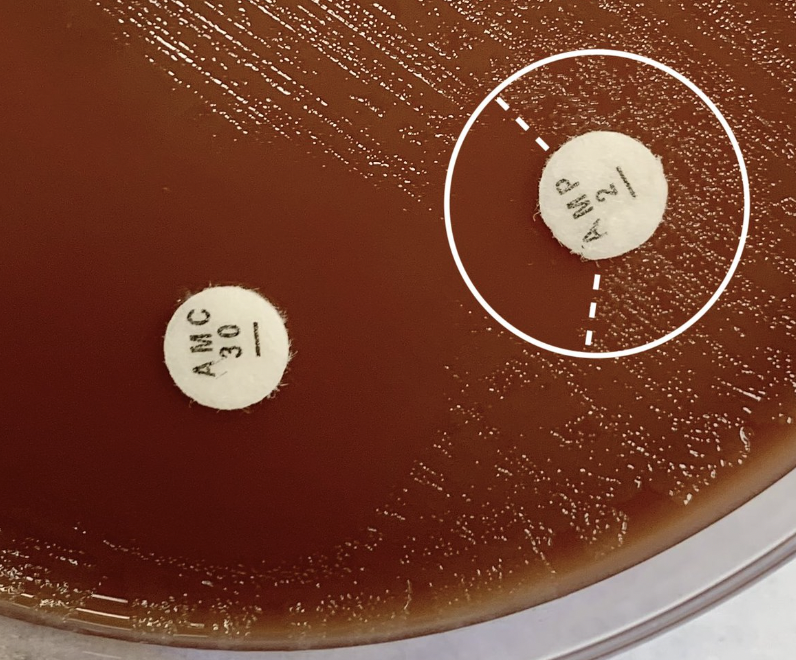
MICROBIOLOGÍA - Hospital Clínico de Valencia tweet media
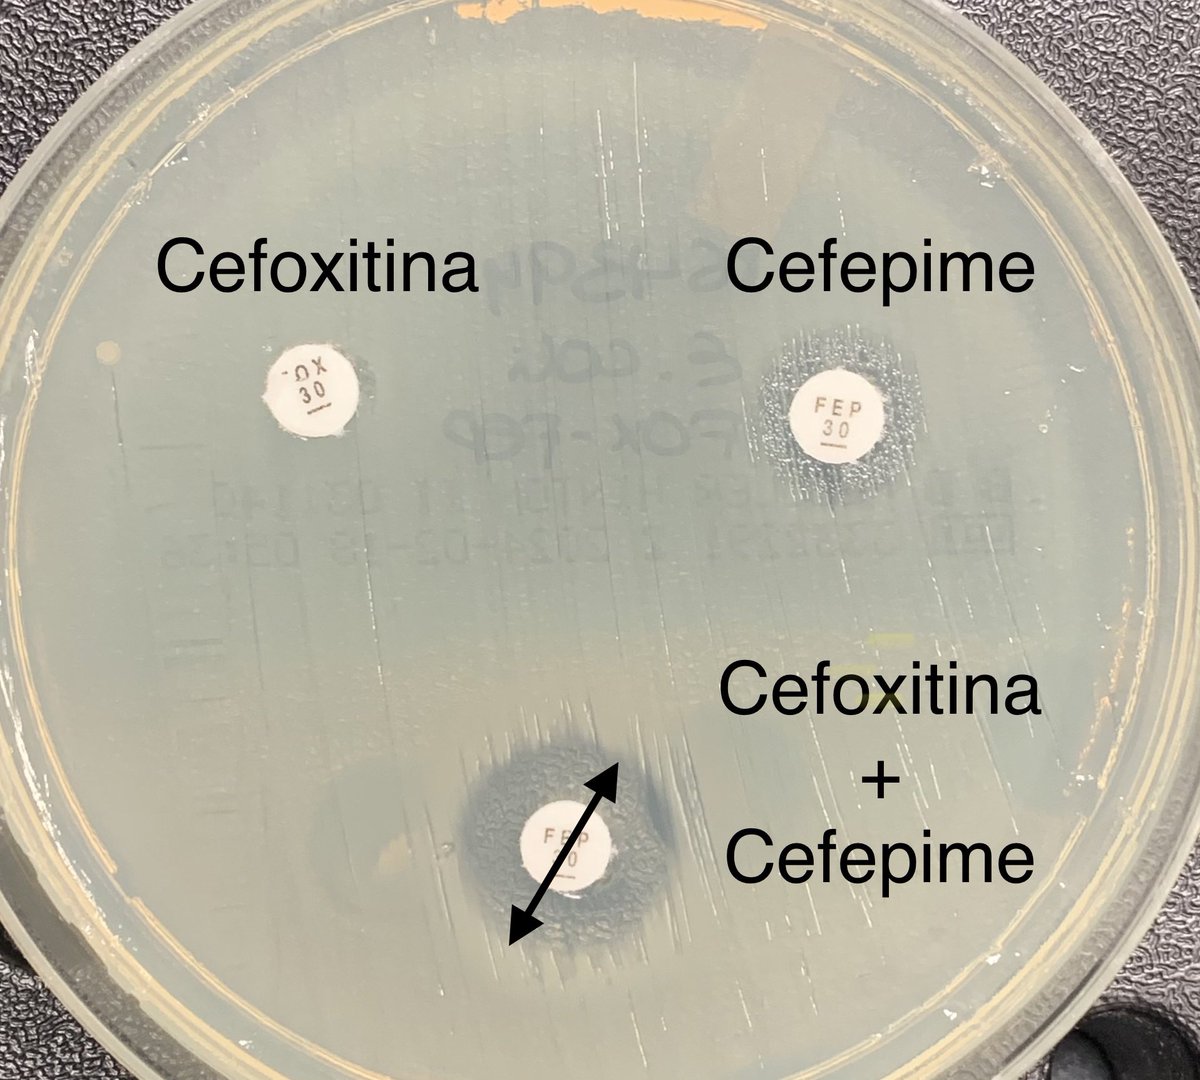
MICROBIOLOGÍA - Hospital Clínico de Valencia tweet media

felfli imene
121 posts


Kicking off our 11th Masterclass with today’s Mini Masterclass 🔥 Featuring the two orang kuat behind it all 💪
#Masterclass11

English
felfli imene retweetledi


@Prev_Infection @HAS_sante Lien PDF s'il vous plaît je le trouve pas sur la plateforme de la HAS
Français

📢 @HAS_sante met à disposition de nouvelles fiches de synthèse préconisant le choix de l’#antibiothérapie et les durées les plus courtes possibles pour les infections bactériennes courantes de ville
> preventioninfection.fr/actualites/has…

Français

La bonne idée avant de partir en congés d'été 🏖️🚞? Consultez le programme préliminaire du congrès 2024 ! A la plage ou à la montagne, commencez à composer votre programme pour la #RICAI !
➡️ bit.ly/3ESnGjW

Français

بداية موسم الحج استفتحنا بكوليرا بعد ١٥ سنه تقريباً رجعنا شفناها تاني بمختبرنا 💔 حبيت اعمل ملخص بسيط عنها ..
#microbiology

العربية

Co-convening this session are Drs. @BurnhamBugDoc and @MicroMeIanie. First up: Dr. Yarbrough is going to take us through urine culture thresholds.


English

Kicking off #ASMicrobe this morning with some great discussions on working up urine and respiratory cultures.

English

The 2024 CLSI M100 document is available online now for free
The updates include
Ceftazidime-avibactam & aztreonam synergy test using Broth Disc Elution Method (finally we have a guide for this)
@Dr_ChrisKCLai @Rasidah @stevenlimcl @shaharudeen @alif82 @adammashraff




English

@charles_cazanav @Genevieve_Hery @PharmacoBx @MathieuMolimard @SFPT_fr @LaureBarthod @LahouatiM @Reseau_CRPV @CRPV_Limoges @yannbubien @nathanpsmad Il est possible de partager la présentation entière ?
Français

#LAntibioDuVendredi
Cette semaine les #Macrolides sont à l’honneur et ils le sont depuis quelques semaines avec cette épidémie de #mycoplasma !
🙏🏼 à Manon pour cette belle synthèse ou elle rappelle les données de vigilance pharmacologique.
L’auditoire était captivé !
@CecileBebear @CHUBordeaux

Bordeaux, France 🇫🇷 Français

Wonderfully practical & highly enjoyable discussion on clinical testing & reporting conundrums to optimize treatment with @SIDPharm panelist Dr. @cynth_ID #IDWeek2023

Justin Moore@moore_wjustin
Great debate of what to do with mecA/PBP2A negative, oxacillin-resistant Staph aureus Cx results A: Expert panel rec’s report & treat as MRSA, given highly elevated oxa MIC as opposed to BORSA that traditionally has MIC of 2 or less. Likely explained by blaZ #IDWeek2023
English

Great debate of what to do with mecA/PBP2A negative, oxacillin-resistant Staph aureus Cx results
A: Expert panel rec’s report & treat as MRSA, given highly elevated oxa MIC as opposed to BORSA that traditionally has MIC of 2 or less. Likely explained by blaZ #IDWeek2023



English